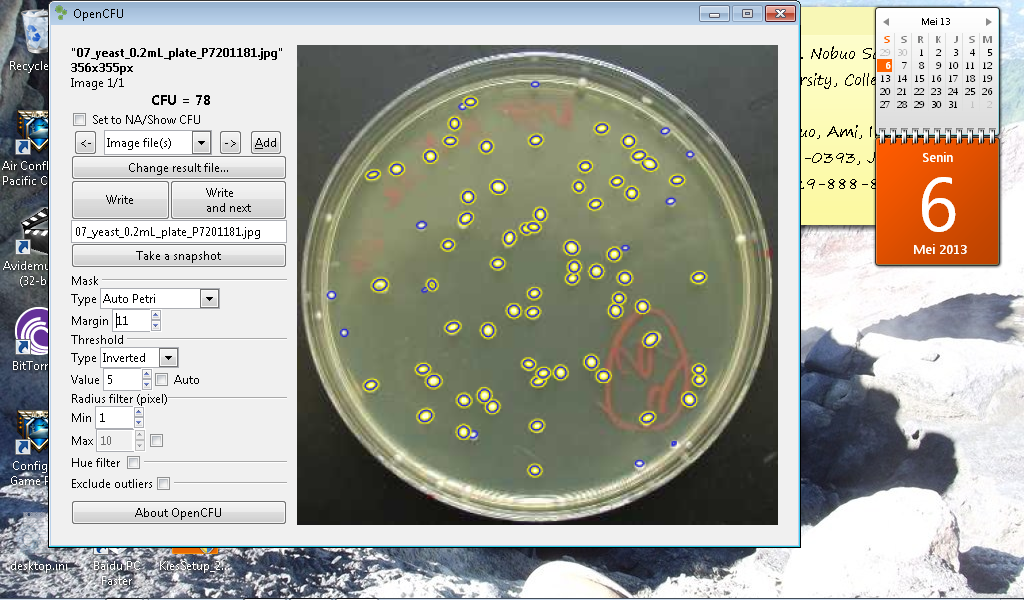

Fecal Indicator bacteria like total coliforms, fecal coliforms (thermotolerant coliforms), E. coli and intestinal enterococci (fecal streptococci) are excreted by humans and warmblooded animals, pass sewage treatment plants to a great amount and survive for a certain time in the aquatic environment (Kavka & Poetsch 2002). E. coli and fecal coliforms are the best indicators for the assessment of recent fecal pollution, mainly caused by raw and treated sewage and diffuse impacts e. g. from farm land and pasture. E.coli and fecal coliforms indicate also the potential presence of pathogenic bacteria, viruses and parasites (Kavka & Poetsch 2002). Detailed knowledge of fecal pollution in aquatic environments is crucial for watershed management activities in order to maintain safe waters for recreational and economic purposes (Farnleitner et al. 2001). Traditionally, the methods used for enumeration of these indicator bacteria are cultured-based total plate count (TPC).
Total Plate Count
The total plate count TPC (aerobic, mesophilic organisms) defines how many aerobic (oxygen-loving), mesophilic (moderate-temperature-loving) micro-organism colonies such as bacteria, yeast and mould fungi will grow in 72 hours on an agar plate that was normed for microbiological testing at a controlled temperature of 30 °C. (Swiss Handbook of Foods / ISO 4833:2003)
Determination
Precisely defined amounts of the sample will be mixed in petri dishes with nutrient solution and kept in an incubator at 30 °C. After 3 days, the colonies grown on the samples will be counted, thereby determining the number of aerobic, mesophilic organisms per g or per ml of sample.The result will be given in colony forming units (cfu/g or cfu/ml).
A colony forming unit is a bacteria or yeast that is capable of living and reproducing to form a group of the same bacteria or yeasts. Microbiologists use CFU to describe the number of active, live organisms instead of the number of all the bacteria – dead, inactive and alive – in a laboratory sample. Only the viable organisms are considered to be probiotics. “Viable” means that the microbes are capable of living under the proper circumstances.
Application
Total plate count could be used to determine the E-coli contamination on river water. Standard plate counts methodes for e-coli determination were performed by using serial dilutions of the water samples in sterile buffered water, followed by preparation of pour plates, using Endo agar in replicates of three. The general ranges in common acceptance for countable numbers of colonies on a plate are 30 – 300 and 25 – 250.
DIY Automatic Colony Counter
Colony Counter is designed for counting colonies growing on medium. Unlike the manual counter, DIY Automatic colony counter has really advanced features of image analysing, but it has very simple interface. So, everybody can use Colony Counter intuitively. The image analysing sofware (openCFU) were open source software compiled by Quentin Geismann. OpenCFU is a free software that should facilitate (and render more reproducible) the enumeration of colony forming unit (CFU). You can simply run the program on your computer and input pictures of plated bacterial colonies (or other cells). The software could be downloaded from http://opencfu.sourceforge.net/.
 OpenCFU is published on PLoS ONE:
OpenCFU is published on PLoS ONE:
http://www.plosone.org/article/info%3Adoi%2F10.1371%2Fjournal.pone.0054072
Meanwhile, the DIY Colony counter hardware designed by Nur Akbar Arofatullah intended to facilitate the OpenCFU software to accurately count the colony. It also provide user-friendly interface so that could be use easily. You can find the design on the Lifepatch site.

Hi, I am the author of OpenCFU, thank you for your post!
I was wondering if you would mind sending me a few pictures of your device and some plate pictures samples that I could include on my website. I also had a few comments :). Please contact me: opencfu@gmail.com.
Hi, interesting to see your experiances, maybe we can help a bit as we are introducting an automatic bacteria growth system based on an enzymatic technique…..
Hi, interesting work. Could you publicate the construction plans of the counter?
Do you perhaps have the plans for constructing the DIY Colony counter hardware too?
Hi, Paulo, hi, Bryan –
thanks for your interest – you can find it in the Lifepatch site – we will bring it up in the text too.
http://lifepatch.org/MiCAM
you can switch the language to English on the menu on the left
Excellent! Thanks 🙂